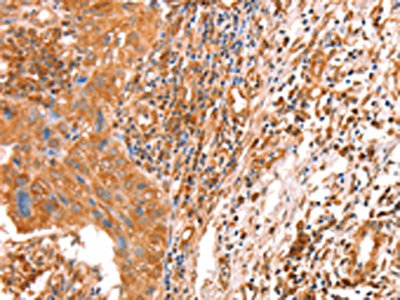

ACAD9 Antibody
-
中文名稱:ACAD9兔多克隆抗體
-
貨號:CSB-PA948378
-
規(guī)格:¥1100
-
圖片:
-
The image on the left is immunohistochemistry of paraffin-embedded Human cervical cancer tissue using CSB-PA948378(ACAD9 Antibody) at dilution 1/10, on the right is treated with fusion protein. (Original magnification: ×200)
-
The image on the left is immunohistochemistry of paraffin-embedded Human thyroid cancer tissue using CSB-PA948378(ACAD9 Antibody) at dilution 1/10, on the right is treated with fusion protein. (Original magnification: ×200)
-
-
其他:
產(chǎn)品詳情
-
Uniprot No.:
-
基因名:
-
別名:ACAD9Complex I assembly factor ACAD9 antibody; mitochondrial antibody; Acyl-CoA dehydrogenase family member 9 antibody; ACAD-9 antibody; EC 1.3.8.- antibody
-
宿主:Rabbit
-
反應(yīng)種屬:Human,Mouse
-
免疫原:Fusion protein of Human ACAD9
-
免疫原種屬:Homo sapiens (Human)
-
標(biāo)記方式:Non-conjugated
-
抗體亞型:IgG
-
純化方式:Antigen affinity purification
-
濃度:It differs from different batches. Please contact us to confirm it.
-
保存緩沖液:-20°C, pH7.4 PBS, 0.05% NaN3, 40% Glycerol
-
產(chǎn)品提供形式:Liquid
-
應(yīng)用范圍:ELISA,IHC
-
推薦稀釋比:
Application Recommended Dilution ELISA 1:2000-1:5000 IHC 1:25-1:100 -
Protocols:
-
儲存條件:Upon receipt, store at -20°C or -80°C. Avoid repeated freeze.
-
貨期:Basically, we can dispatch the products out in 1-3 working days after receiving your orders. Delivery time maybe differs from different purchasing way or location, please kindly consult your local distributors for specific delivery time.
-
用途:For Research Use Only. Not for use in diagnostic or therapeutic procedures.
相關(guān)產(chǎn)品
靶點(diǎn)詳情
-
功能:As part of the MCIA complex, primarily participates in the assembly of the mitochondrial complex I and therefore plays a role in oxidative phosphorylation. This moonlighting protein has also a dehydrogenase activity toward a broad range of substrates with greater specificity for long-chain unsaturated acyl-CoAs. However, in vivo, it does not seem to play a primary role in fatty acid oxidation. In addition, the function in complex I assembly is independent of the dehydrogenase activity of the protein.
-
基因功能參考文獻(xiàn):
- Mutations in the ND6, NDUFV1 or ACAD9 genes are responsible for the mitochondrial complex I deficiency. PMID: 29348607
- Study identified new mutations in ACAD9 responsible for a wide spectrum of heart diseases in the presence of elevated serum lactate levels. PMID: 27233227
- ACAD9 mutation is the most frequent cause of cardiac hypertrophy and isolated complex I deficiency. PMID: 26669660
- Case Report: neonatal multiorgan failure due to ACAD9 mutation and complex I deficiency with mitochondrial hyperplasia in liver, cardiac myocytes, skeletal muscle, and renal tubules. PMID: 26826406
- In cells where it is strongly expressed, ACAD9 plays a physiological role in fatty acid oxidation. PMID: 25721401
- Our results underscore the importance of the ACAD9 protein in complex I assembly and suggest that the enzymatic activity is a rudiment of the duplication event. PMID: 24158852
- Our data support a new function for ACAD9 in complex I function, making this gene an important new candidate for patients with complex I deficiency, which could be improved by riboflavin treatment. PMID: 20929961
- ACAD9 screening of 120 additional complex I-defective index cases led us to identify two additional unrelated cases and a total of five pathogenic ACAD9 alleles. PMID: 21057504
- Data show that two closely related metabolic enzymes, ACAD9 and VLCAD, diverged at the root of the vertebrate lineage to function in two separate mitochondrial metabolic pathways and have clinical implications for the diagnosis of complex I deficiency. PMID: 20816094
- Very high activity of CPT2 and VCLAD, involved in the metabolism of long-chain fatty acids. Fatty acid oxidation may play role in energy generation in placenta, and deficiency in may result in placental dysfunction and gestational complications. PMID: 12971426
- ACAD9 may play a role in the turnover of lipid membrane unsaturated fatty acids that are essential for membrane integrity and structure PMID: 16020546
- acyl-CoA dehydrogenase 9 (ACAD 9)was identified as the long-chain ACAD in human embryonic and fetal brain and central nervous tissue, using in situ hybridization as well as enzymatic studies PMID: 16750164
- We now report three cases of ACAD9 deficiency. PMID: 17564966
- Accumulation of 3-hydroxylated intermediates of long-chain fatty acids may contribute to the pathogenesis of retinopathy in MTP deficiencies. PMID: 18385088
- Validated occurrence of an unusual TG 3' splice site in intron 10. PMID: 17672918
顯示更多
收起更多
-
相關(guān)疾病:Acyl-CoA dehydrogenase family, member 9, deficiency (ACAD9 deficiency)
-
亞細(xì)胞定位:Mitochondrion inner membrane; Peripheral membrane protein; Matrix side.
-
蛋白家族:Acyl-CoA dehydrogenase family
-
組織特異性:Ubiquitously expressed in most normal human tissues and cancer cell lines with high level of expression in heart, skeletal muscles, brain, kidney and liver. In the cerebellum uniquely expressed in the granular layer (at protein level).
-
數(shù)據(jù)庫鏈接:
Most popular with customers
-
-
YWHAB Recombinant Monoclonal Antibody
Applications: ELISA, WB, IHC, IF, FC
Species Reactivity: Human, Mouse, Rat
-
-
-
-
-
-